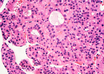
HCC
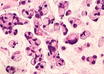
esophageal cancer

Organ transplantation in more medical colleges of Bengal
UNI | Jan 22, 2019
Objective response as a surrogate for OS could offer advantages in patients with HCC: 2019 Gastrointestinal Cancers Symposium
Gastrointestinal Cancers Symposium News | Jan 22, 2019
Combination immune checkpoint inhibition and SBRT for advanced pancreatic cancer: 2019 Gastrointestinal Cancers Symposium
Gastrointestinal Cancers Symposium News | Jan 22, 2019
Adjuvant treatment with Durvalumab for locally advanced esophageal & GEJ cancers helps prevent relapse: 2019 Gastrointestinal Cancers Symposium
Gastrointestinal Cancers Symposium News | Jan 22, 2019
Himachal CM, Union Health Minister perform ground breaking ceremony of AIIMS
IANS | Jan 22, 2019
Novel hope for stem cell approach to treat diabetes
IANS | Jan 22, 2019
Bengal Govt revamping health infrastructure in the Hills
UNI | Jan 22, 2019
No move to hand over rural health centres to private players in Punjab: Minister
IANS | Jan 22, 2019
Most read this week